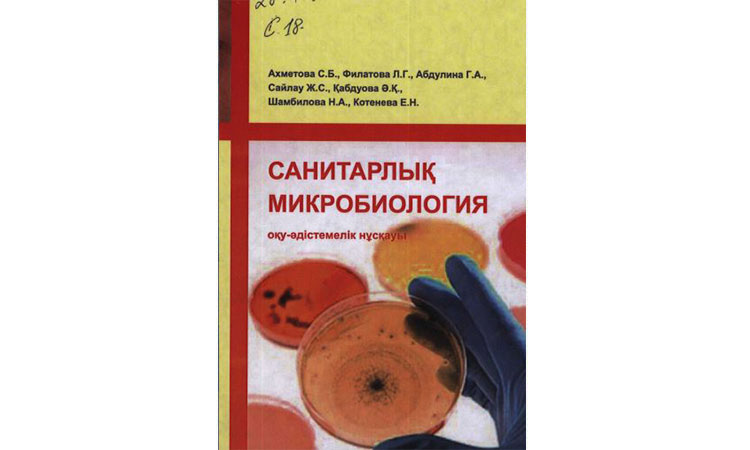

Ахметова С.Б., Филатова Л.Г., Абдулина Г.А., Сайлау Ж.С., Қабдуова Ә.Қ., Шамбилова Н.А., Котенева Е.Н. Санитарлық микробиология. Оқу-әдістемелік нұсқауы. – Алматы, «ССК» баспасы, 2020.-100 б.
Ахметова С.Б., Филатова Л.Г., Абдулина Г.А., Сайлау Ж.С., Қабдуова Ә.Қ., Шамбилова Н.А., Котенева Е.Н. Санитарлық микробиология. Оқу-әдістемелік нұсқауы. – Алматы, «ССК» баспасы, 2020.-100 б.
Оқу әдістемелік құралында қоршаған ортаның микробиологиясының негізгі құрамында ҚР аумағында қалыптасқан стандарттар негізінде құрастырылған. Оқу әдістемелік құралында қазіргі уақыттағы қолданып жүрген санитарлық микробиологиялық әдістер қолданады.